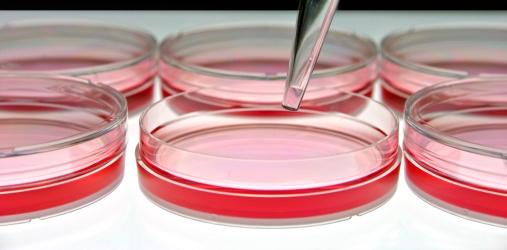

Il bando del Programma Horizon 2020 BIOTEC-5a-2014-fase1 “SME boosting biotechnology-based industrial processes driving competitiveness and sustainability” implementa lo schema di finanziamento dello SME Instrument, finanziato per il 70% dei costi totali eleggibili.
Le PMI che caratterizzano il settore biotecnologico EU, giocano un ruolo cruciale per la competitività e la sostenibilità dei processi biotecnologici. Queste PMI sono caratterizzate da un’elevata intensità di ricerca e da lunghi tempi che intercorrono tra l’inizio dello sviluppo tecnologico e l’introduzione sul mercato. La sfida principale è dunque quella di offrire supporto alle PMI per permettere loro di superare la cosiddetta valle della morte.
L’obiettivo specifico della ricerca e dell’innovazione nel settore delle biotecnologie è sviluppare prodotti e processi industriali competitivi, sostenibili, sicuri e innovativi come prodotti chimici, industria mineraria, energia, salute, pasta e carta, legna e prodotti a base di fibre, tessile, amido, trasformazione alimentare.
L’obiettivo specifico della ricerca e dell’innovazione nel settore delle biotecnologie è sviluppare prodotti e processi industriali competitivi, sostenibili, sicuri e innovativi come prodotti chimici, industria mineraria, energia, salute, pasta e carta, legna e prodotti a base di fibre, tessile, amido, trasformazione alimentare.
Per le proposte nella fase 1 dello SME Instrument, l’obiettivo è quello di sviluppare uno studio di fattibilità che verifichi la fattibilità tecnologica/pratica oltre che economica di una idea/concetto considerevolmente innovativa per il settore in cui viene presentata (nuovi prodotti, processi, progettazione, servizi e tecnologie o nuove applicazioni di mercato di tecnologie esistenti). Gli impatti attesi:
- Migliorare le performance di redditività e crescita delle PMI combinando e trasferendo conoscenze nuove ed esistenti in soluzioni innovative, dirompenti e competitive cogliendo le opportunità di business europei e mondiali;
- Diffusione sul mercato e distribuzione di innovazioni che affrontano le sfide di incentivare processi industriali basati sulle biotecnologie che guidano competitività e sostenibilità;
- Aumento degli investimenti privati in innovazione.
Le calls dello SME Instrument sono continuamente aperte ed organizzate con date di cut-off intermedie ogni anno. Le applicazioni possono essere sottomesse in qualsiasi momento. La prossima deadline nel 2014 per la fase1 è fissata al 17/12/2014. La Commissione Europea rimborsa i costi sostenuti per la fase 1 sotto forma di somma forfettaria: l’ammontare del finanziamento è stabilito a €50.000.
©RIPRODUZIONE RISERVATA
©RIPRODUZIONE RISERVATA



